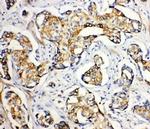
SERCA2 ATPase Antibody in Immunohistochemistry (Paraffin) (IHC (P))

Search
Invitrogen
SERCA2 ATPase Polyclonal Antibody
{{$productOrderCtrl.translations['antibody.pdp.commerceCard.promotion.promotions']}}
{{$productOrderCtrl.translations['antibody.pdp.commerceCard.promotion.viewpromo']}}
{{$productOrderCtrl.translations['antibody.pdp.commerceCard.promotion.promocode']}}: {{promo.promoCode}} {{promo.promoTitle}} {{promo.promoDescription}}. {{$productOrderCtrl.translations['antibody.pdp.commerceCard.promotion.learnmore']}}
图: 1 / 5
SERCA2 ATPase Antibody (PA5-78836) in ICC/IF

Please note: We are reviewing Western blot images included in the antibody testing data in our catalog, including those provided by third parties. Unless expressly labeled or annotated as “raw-unedited”, Western blot images included in the antibody testing data in our catalog may have been edited, optimized or otherwise adjusted for presentation.
产品信息
PA5-78836
种属反应
已发表种属
宿主/亚型
分类
类型
抗原
偶联物
形式
浓度
规格
纯化类型
保存液
内含物
保存条件
运输条件
RRID
产品详细信息
Reconstitute with 0.2 mL of distilled water to yield a concentration of 500 µg/mL.
Positive Control - WB: Rat Skeletal Muscle Tissue, Rat Kidney Tissue, PANC Cell, SMMC Cell. IHC: Human Mammary Cancer Tissue.
靶标信息
This gene encodes one of the SERCA Ca(2+)-ATPases, which are intracellular pumps located in the sarcoplasmic or endoplasmic reticula of muscle cells. This enzyme catalyzes the hydrolysis of ATP coupled with the translocation of calcium from the cytosol into the sarcoplasmic reticulum lumen, and is involved in regulation of the contraction/relaxation cycle. Mutations in this gene cause Darier-White disease, also known as keratosis follicularis, an autosomal dominant skin disorder characterized by loss of adhesion between epidermal cells and abnormal keratinization. Alternative splicing results in multiple transcript variants encoding different isoforms.
⚠WARNING: This product can expose you to chemicals including mercury, which is known to the State of California to cause birth defects or other reproductive harm. For more information go to www.P65Warnings.ca.gov.
仅用于科研。不用于诊断过程。未经明确授权不得转售。
生物信息学
蛋白别名: ATPase, Ca++ transporting, slow twitch 2; Calcium pump 2; Calcium-transporting ATPase sarcoplasmic reticulum type, slow twitch skeletal muscle isoform; Endoplasmic reticulum class 1/2 Ca(2+) ATPase; sarco(endo)plasmic reticulum Ca(2+)-dependent ATPase 2; sarco/endoplasmic reticulum Ca2+-ATPase 2; Sarcoplasmic/endoplasmic reticulum calcium ATPase 2; SERCA; SERCA ATPase; SERCA2; SR Ca(2+)-ATPase 2
基因别名: 9530097L16Rik; ATP2A2; ATP2B; D5Wsu150e; mKIAA4195; SERCA2; Serca2a; SERCA2B; SercaII
UniProt ID: (Mouse) O55143, (Rat) P11507
Entrez Gene ID: (Mouse) 11938, (Rat) 29693




